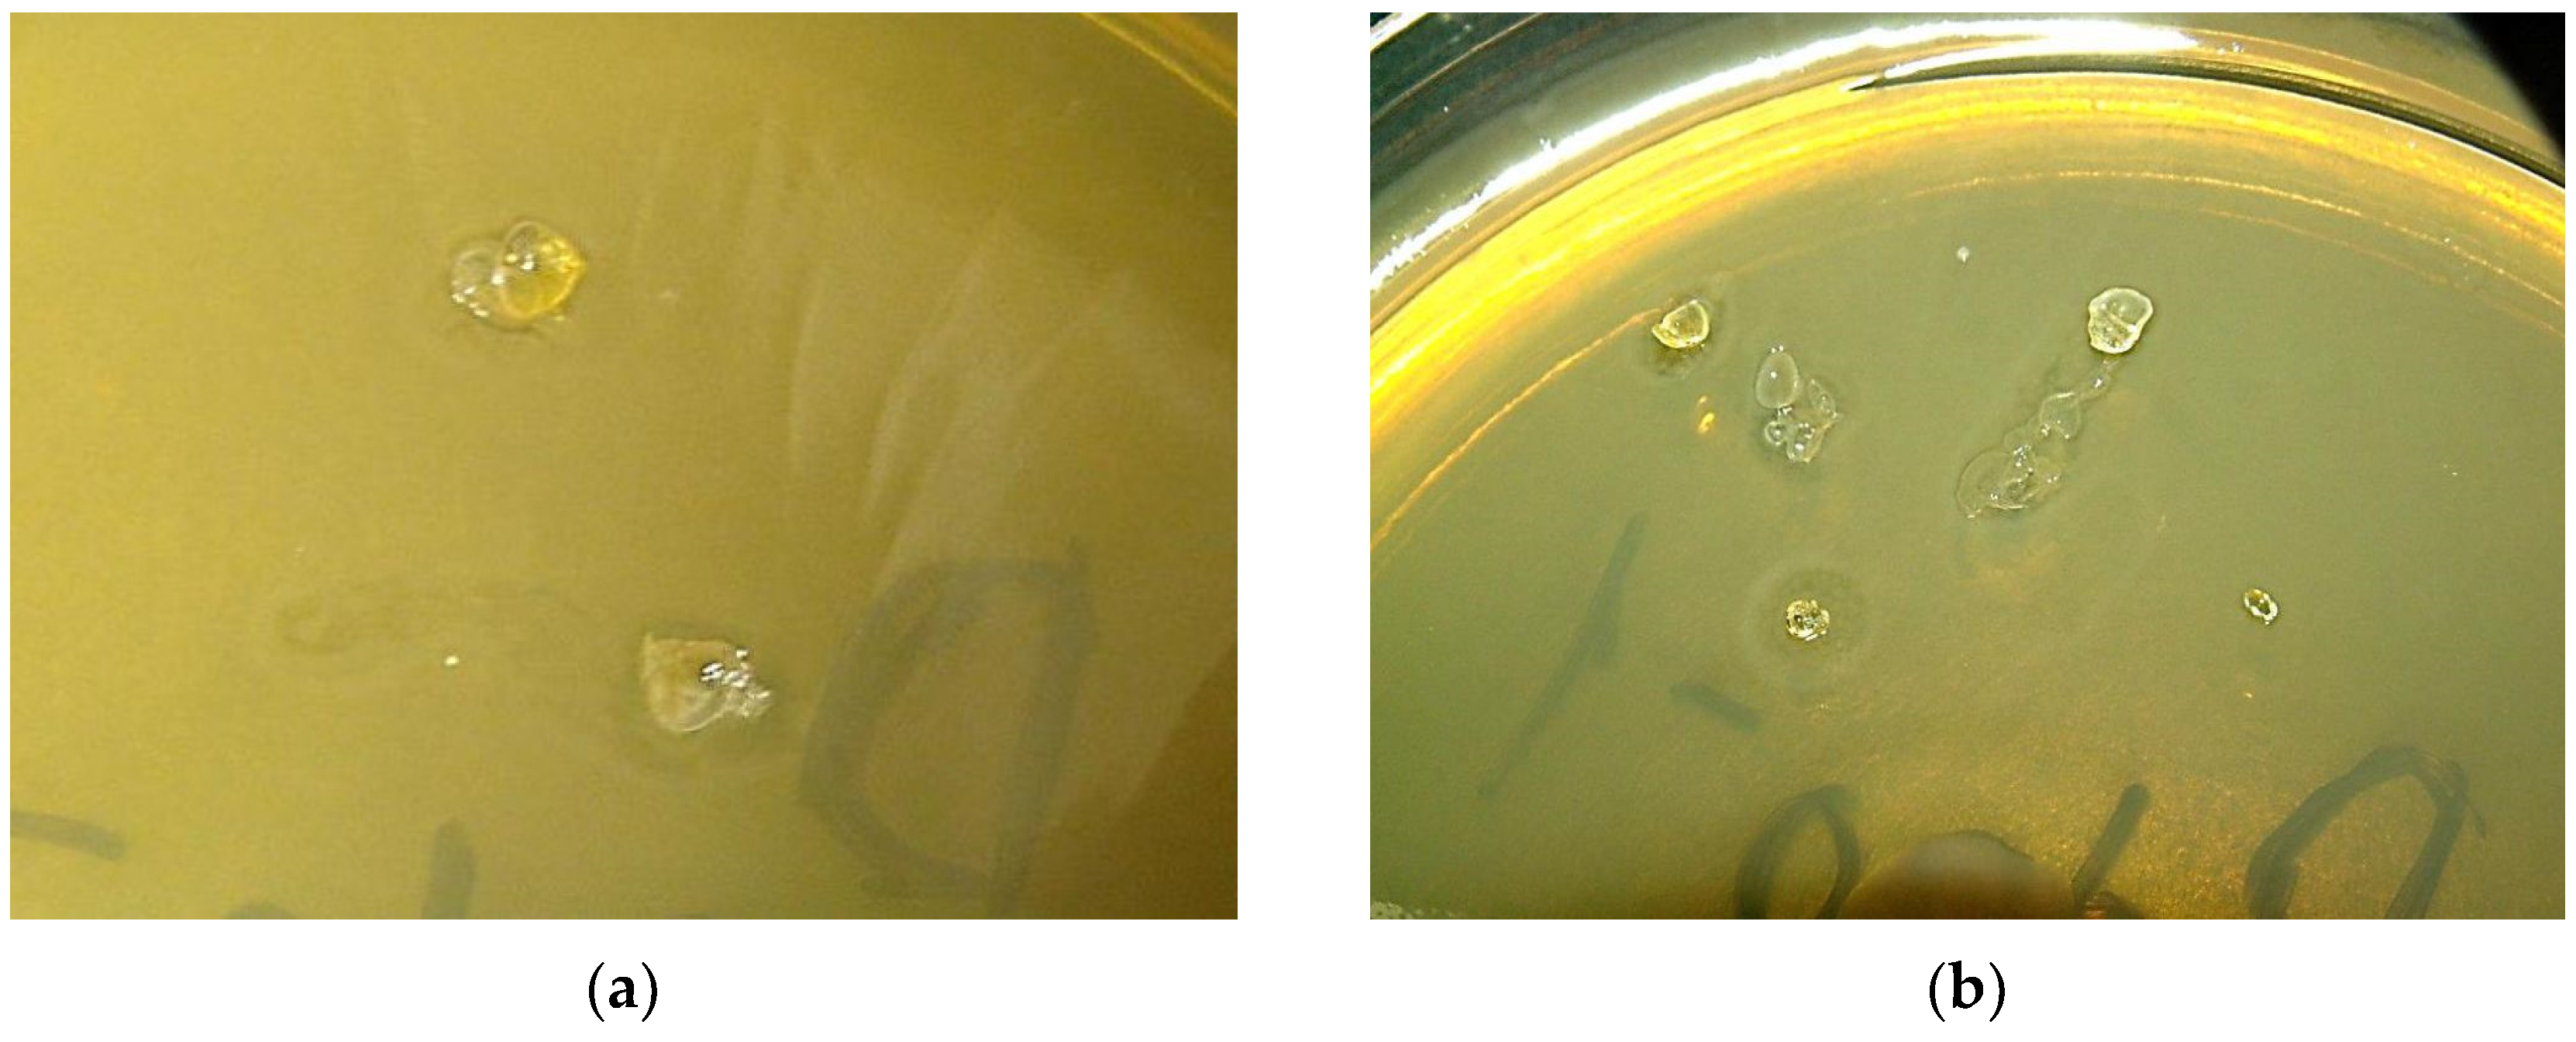
Preprints 91598 g001

1. Introduction
Nowadays, the search for new anticancer drugs is an actual task. Along with small molecules, polymer compounds are being actively studied as potential bioactive compounds [
1,
2,
3,
4,
5].
Hyperbranched polymers (HBPs) are the type of polymers with globular and three-dimensional non regular macromolecular structure. Due to their structure, HBPs have unique physical and chemical properties. The sizes of macromolecules vary from several to tens of nanometers and are characterized by a high density of functional groups, low viscosity and high solubility compared to linear and branched polymers of a similar structure [
6]. Despite the similarity of the structure and properties of HBPs to dendrimers, their synthesis is much simpler and easier to scale [
7].
The unique structural properties and accessibility explain the active exploration of their properties for use in biological and medical applications as fluorescent polymers [
8], nanocontainers for drug delivery to cancer tumors [
9], photosensitizers for photodynamic therapy [
10], nanomaterials for cancer diagnostics [
11].
There are several obtaining approaches for HBPs [
12]. Previously, we demonstrated the possibility of obtaining HBPs in bulk using a simple thermal azide-alkyne cycloaddition of a AB
2 type 1,3,5-triazine monomers [
13,
14].
The goal of this work is the study the cytotoxicity and antibacterial activity of propargyloxy substituted 1,3,5-triazines: monomers and HBPs based on them [
14] to assess their applicability in biomedical applications.
2. Materials and Methods
2.1. General Information
Commercially available reagents (cyanurchloride, 2-propynol, hydrazine hydrate, NaN3, NaNO2, NaHCO3, NaOH, HCl) and solvents (acetone, isopropanol, DMSO, CH2Cl2) (Aldrich, Acros, Fluka) were used without preliminary purification, Na2SO4 was calcined, THF dried over KOH and distilled over CaH2. The melting point was measured on a Boetius-type heating table with a heating rate of 4 °C∙min-1 at the melting point. IR spectra were recorded on an Alpha Bruker FT-IR spectrometer; solid samples were prepared in the form of KBr tablets; IR spectra of solutions were recorded in dismountable CaF2 cuvettes. NMR spectra were recorded on a superconducting pulsed broadband two-channel NMR spectrometer AVANCE III 500 MHz Bruker BioSpin for liquid-phase samples, at 500 MHz (1H spectra) and 126 MHz (13C spectra) for samples in DMSO-d6 and CDCl3 with 1% tetramethylsilane (TMS). Elemental analysis was performed on a CHNS/O elemental analyzer “Vario Micro cube” Elementar GmbH. The optical density of MTT-formazan dissolved in DMSO was measured on an EFOS 9305 immunoenzyme tablet photometer (JSC "MZ "Sapphir", Russia) at a wavelength of 570 nm. Nonspecific sorption was measured at a wavelength of 650 nm.
2.2. Synthesis of 2,4,6-trispropargyloxy-1,3,5-triazine (3)
In a 250 ml three-neck 10.00 g (54 mmol) of cyanuric chloride, 10.12 g (180 mmol) of 2-propynol (molar ratio of 2-propynol: cyanuric chloride = 1:3.33) were mixed in 130 ml of acetone at 20 oC. After complete dissolution, the mixture was cooled to 0−2 °C. 5% NaOH solution was added to the mixture, adjusting its supply so that the temperature of the mixture didn’t rise above 5 °C. The completion of the reaction was checked using the Belstein’s test (the absence of chlorine in the sample of the substance). After complication of the reaction, the solvent was removed under reduced pressure, the resulting white precipitate was washed with water and dried on air. Yield 8.90 g (69%). Colorless crystals, mp. 79–80 °C (i-PrOH). IR spectrum (KBr tablet), ν, cm-1: 3267 (≡CH), 2965, 2938 (stretching vibrations of CH2), 2135 (-C≡CH), 1571 (stretching vibrations of C-N triazine), 1452 (deformation CH2 vibrations), 1135, 1332 (stretching vibrations of C-O-C), 816 (bending vibrations of C-N triazine). 1H NMR spectrum (500 MHz, DMSO-d6), δ, ppm. (J, Hz): 3.64 (3H, t, J = 2.4, CH); 5.06 (6H, d, J = 2.4, CH2). 13C NMR (126 MHz, CDCl3), δ, ppm: 172.46; 77.16; 75.95; 55.94. Found, %: C 59.08; H 3.86; N 17.02. C12H9N3O3 calculated, %: C 59.26; H 3.73; N 17.28.
2.3. Synthesis of 2-hydrozino-4,6-dipropargyloxy-1,3,5-triazine (4)
In a 100 ml flask 10.0 g (41 mmol) of compound 3 were dissolved in 37 ml of i-PrOH and 16 ml of THF and 2.83 ml (57 mmol) of hydrazine hydrate was added. The mixture was stirred for 2 hours at room temperature. The resulting mixture was filtered, the precipitate was washed with 12 ml of i-PrOH and dried on air. Yield 7.75 g (86%). White crystals, mp. 141−143 oC. IR spectrum (KBr tablet), ν, cm-1: 3351, 3222, 3181, 3116 (-NHNH2), 3294 (≡CH), 2135, 2122 (stretching vibrations -С≡CH), 1673, 1608 (bending vibrations of NHNH2), 1583, 1544 (stretching vibrations -C=N of triazine), 1461 (bending vibrations of CH2), 1332, 1112 (stretching vibrations of C-O-C), 813 (bending vibrations -C=N of triazine). 1H NMR spectrum (500 MHz, DMSO-d6), δ, ppm: 3.56 (1H, t, J = 1.9, CH); 3.58 (1H, t, J = 1.9, CH); 4.44 (2H, s, NH2); 4.94 (2H, d, J = 1.9, CH2); 5.02 (2H, d, J = 1.9, CH2); 9.15 (1H, m, NH). 13C NMR spectrum (126 MHz, DMSO-d6), δ, ppm: 170.66; 168.96; 78.83; 78.06; 54.52. Found, %: C 48.79; H 4.28; N 31.60. C9H9N5O2. Calculated, %: C 49.31; H 4.14; N 31.95.
2.4. Synthesis of 2,4-dihydrozino-6-propargyloxy-1,3,5-triazine (5)
In a 100 ml flask 10.0 g (41 mmol) of compound 3 was dissolved in 74 ml of i-PrOH and 5.65 ml (114 mmol) of hydrazine hydrate was added. The mixture was refluxed for 3.5 hours. The resulting mixture was filtered, the precipitate was dried on air. Yield 7.84 g (98%). White crystals, mp. 188 – 189 oC. IR spectrum (KBr tablet), ν, cm-1: 3324 (≡CH), 3341 (NH), 3236, 3169 (NH2), 2121 (-С≡CH), 1667, 1598 (bending vibrations of NHNH2), 1584, 1541 (stretching vibrations of -C=N triazine), 1456 (bending vibrations of CH2), 1328, 1106, (stretching vibrations of C-O-C), 805 (bending vibrations of -C=N triazine). 1H NMR spectrum (500 MHz, DMSO-d6), δ, ppm: 3.49 (1H, s, CH); 4.08-4.50 (4H, m, NH2); 4.78-5.12 (2H, m, CH2); 8.20-8.62 (2H, m, NH). 13C NMR spectrum (126 MHz, DMSO-d6), δ, ppm: 168.43; 79.81; 77.80; 53.83. Found (%): C 36.56; H 4.93; N 50.75. C6H9N7O. Calculated (%): C 36.92; H 4.65; N 50.23.
2.5. Synthesis of 2-azido-4,6-dipropargyloxy-1,3,5-triazine (1)
The solution of 10.0 mmol of concentrated HCl in 5 ml of water was added to suspension 1.53 g (7.0 mmol) of hydrazine 4 in 10 ml of water with cooling (bath of ice and salt) and the mixture was stirred until dissolved. 10 ml of CH2Cl2 was added, and a solution of 0.48 g (7.0 mmol) NaNO2 in 2 – 3 ml of water were dropwise added. Reaction mixture was stirred for 10 minutes with cooling, then add NaHCO3 until neutral. The organic layer was separated, the aqueous layer was extracted with CH2Cl2 (2x10 ml), the organic layer is washed with a saturated aqueous solution of NaHCO3 (2x25 ml) and dried over calcined Na2SO4. A solution of the substance in CH2Cl2 is passed through a thin layer of silica gel, and the solvent is distilled off on a rotary evaporator.
Yield 1.29 g (80%). White crystals, mp. 40–41
oC (CH
2Cl
2) (mp 40-41
oC [
15]). IR spectrum (KBr tablet), ν, cm
-1: 3278 (≡CH), 2159, 2132, 1332 (stretching vibrations of N
3), 1583, 1548 (stretching vibrations -C=N of triazine), 1489 (bending vibrations of CH
2), 1381, 1054, (stretching vibrations of C-O-C), 814 (bending vibrations -C=N of triazine).
1H NMR spectrum (500 MHz, DMSO-d
6), δ, ppm. (J, Hz): 3.66 (2H, t, J = 2.3, CH), 5.06 (4H, d, J = 2.3, CH
2).
13C NMR spectrum (126 MHz, DMSO-d
6), δ, ppm: 171.84; 171.60; 78.73; 77.69; 55.96. Found, %: C 46.81; H 2.83; N 37.18. C
9H
6N
6O
2. Calculated, %: C 46.96; H 2.63; N 36.51.
2.6. Synthesis of 2,4-diazido-6-propargyloxy-1,3,5-triazine (2)
The solution of 20.0 mmol of concentrated HCl in 5 ml of water was added to suspension 1.37 g (7.0 mmol) of dihydrazine 5 in 10 ml of water with cooling (bath of ice and salt) and the mixture was stirred until dissolved. 10 ml of CH2Cl2 was added, and a solution of 0.99 g (14.4 mmol) NaNO2 in 2 – 3 ml of water were dropwise added. Reaction mixture was stirred for 15 minutes with cooling, then add NaHCO3 until neutral. The organic layer was separated, the aqueous layer was extracted with CH2Cl2 (2x10 ml), the organic layer is washed with a saturated aqueous solution of NaHCO3 (2x25 ml) and dried over calcined Na2SO4. A solution of the substance in CH2Cl2 is passed through a thin layer of silica gel, and the solvent is distilled off on a rotary evaporator.
Yield 1.17 (77%). White crystals, mp. 57–58 °C (mp. 57–58 [
14]). IR spectrum (KBr tablet), ν, cm
-1: sq. 3277 (≡CH), 2180, 2140, 1352 (stretching vibrations of N
3), 1594, 1547 (stretching vibrations -C=N of triazine), 1451 (bending vibrations of CH
2), 1360, 1076, (stretching vibrations of C-O-C), 809 (bending vibrations -C=N of triazine).
1H NMR spectrum (500 MHz, CDCl
3), δ, ppm. (J, Hz): 2.62 (1H, t, J = 2.4, CH); 5.07 (2H, d, J = 2.4, CH
2).
13C NMR spectrum (126 MHz, CDCl
3), δ, ppm: 172.15; 171.53; 77.51; 77.25; 56.20. Found, %: C 33.41, H 1.89, N 57.20. C
6H
3N
9O. Calculated, %: C 33.19, H 1.39, N 58.05.
2.7. Synthesis of Hyperbranched Polymers (HBP-1 and HBP-2) in Bulk
The thermally initiated polycycloaddition reaction of monomers 1 and 2 was carried out by stepwise heating: 2 hours at a temperature of 60 °C, 2 hours at 90 °C and 10 hours at 120 °C.
2.8. Determination of Compound’s Solubility in Nutrient Media
Weighed portion of the compound under study was dissolved in the required amount of DMSO to obtain solution with an initial concentration of the compound of 10 wt. %. Then this solution was added dropwise to the MEM nutrient medium in such an amount that [DMSO] ≈ 0.1 vol.%. If the solution is colloid (the cone of light from the laser beam became noticeable), then the solution of the test compound in DMSO was diluted and the entire procedure was repeated until the solution become optically clean in a mixture of 99.9 vol.% nutrient medium/0.1 vol. % DMSO.
2.9. Antibacterial Activity of Polymer Films
The volumetric samples of HBPs (10-15 mg) were placed on the surface of an agar inoculated with E. coli bacteria for qualitatively assess the antibacterial activity of polymers. After this, the cups were kept in a thermostat at a temperature of 37 °C for 24 hours. Then the area of the microbial growth inhibition zone was determined.
2.10. Antibacterial Activity by the Disk Diffusion Method (DDM)
Determination of the antibacterial activity of samples was carried out in accordance with the methodology [
20]. 20 ml of melted nutrient agar was poured into sterile Petri dishes with a diameter of 10 cm. A solution of the test
E. coli culture at a concentration of 10
7 pcs/ml was evenly distributed over the surface of the dish, excess liquid was removed with a Pasteur pipette and the agar was dried on the work table with the dish closed. 5 μl of solutions of the studied low-molecular substances in various concentrations in acetone are dosed onto filter paper disks with a diameter of 8 mm.
To take into account the results, determine the width of the microbial growth inhibition zone around the discs using a caliper. The absence of a zone of microbial growth inhibition indicates the resistance of the studied bacteria to this substance. Zones whose diameter does not exceed 15 mm (when using discs with a diameter of 8 mm) indicate poor sensitivity. Zones from 15 to 25 mm are found in sensitive microbes. Highly sensitive microbes are characterized by zones with a diameter greater than 25 mm.
2.11. Cytotoxicity Test by the MTT Test
Researches were carried out on M-HeLa (subclone M, epithelioid carcinoma of the human cervix), FetMSC (mesenchymal stem cells from the bone marrow of a 5−6 weeks embryo) and Vero (African green monkey kidney cells) cell lines. Cell lines were obtained from the Institute of Cytology RAS (St. Petersburg). The M-HeLa cells were grown in EMEM medium (PanEco, Russia), FetMSC cells were grown in DMEM/F12 medium (PanEco), Vero cells were grown in DMEM medium (PanEco). Cells were cultured in media containing 10% fetal calf serum (Biowest, France), penicillin (100 U/ml) and streptomycin (100 mg/ml) in an atmosphere of 5% CO2 at 37°C.
Determination of the cytotoxicity of the test samples with 3-(4,5-dimethylthiazol-2-yl)-2,5-diphenyl-tetrazolium bromide (MTT) was carried out in accordance with the described method [
21].
M-HeLa and
Vero cells were seeded into 96-well plates at a rate of 5∙10
3 cells per well.
FetMSC cells were seeded at 10·10
3 cells per well. The test substances were added to the culture medium 24 hours after seeding in the form of a solution in a mixture of nutrient medium/DMSO (0.1%) in various concentrations. MTT was added to a final concentration of 0.5 mg/ml 72 hours after adding the test compounds to the culture medium and the cells are incubated in an atmosphere of 5% CO
2 at 37°C for 3 hours. The incubation medium and the formed crystals of MTT-formazan were removed from the wells after MTT staining. The color intensity was determined photometrically at a wavelength of 570 nm and a reference wavelength of 620 nm. Cell viability is assessed by MTT staining. The intensity of MTT staining in control samples is taken as 100%. IC
50 doses were calculated using median effect analysis based on dose-response data [
22].
The MTT test is carried out with three repetitions of the experiments. Data from independent experiments was presented as mean ± standard deviation.
3. Results and Discussion
3.1. Optimization of the Method for the Synthesis of Azido-Propargyloxy Monomers
Despite the fact that the studied monomers were obtained and described earlier, the methods of their synthesis provided only low yields (
Scheme 1) [
14,
15].
The method we previously developed for the synthesis of monomer
1 consisted of obtaining 2-azido-4,6-dichloro-1,3,5-triazine and subsequent replacement of chlorine atoms with propargyloxy groups [
14]. This approach made it possible to obtain monomer
1 in two stages, but gave a low total yield (18%). Besides, it was necessary to use column chromatography on the stage of isolating the final product
1. For monomer
2, a two-stage preparation method was also previously used, including the synthesis of 2-propargyloxy-4,6-dichloro-1,3,5-triazine from cyanuric chloride and propargyl alcohol using collidine as a base and further interaction of the resulting dichloride with sodium azide [
15]. Attempts to improve this method (replacing collidine with sodium carbonate and high-boiling toluene with methylene chloride) only reduced the synthesis time and simplified the isolation of product
2, but didn’t increase the total yield (29%). The main reason for the relatively low total yield of monomers was the nonselectivity of substitution of chlorine atoms in cyanuric chloride and 2-azido-4,6-dichloro-1,3,5-triazine with propargyloxy groups (in general, with alkoxy groups). In the result, mixtures of products require vacuum distillation or column chromatography for the separation of target compounds. It is known that the replacement of chlorine in cyanuric chloride with an alkoxy group(s) only slightly reduces the ability of the remaining chlorine atoms to undergo nucleophilic substitution, which leads to a sharp decrease in the mobility of the remaining chlorine atoms. This fact allows selective mono-, di- or trireplacement of chlorine atoms in cyanuric chloride with amino groups [
17,
18].
In this work, a new general procedure for the synthesis of monomers
1 and
2 was developed and significantly increased the yield of target products and made it easier to their isolation. At the first stage, trisubstituted 1,3,5-triazine
3 was synthesized from cyanuric chloride according to the method of [
16]. Then one or two propargyloxy groups were replaced by hydrazino groups. In the third step, the reaction of nitrosation of hydrazino-1,3,5-triazines
4 and
5 was carried out according to the method [
19] with sodium nitrite in the hydrochloric acid. (
Scheme 2). As a result, target products were obtained with a significantly higher overall yield (48% for
1 and 52% for
2) than previously (18% and 29%, respectively) from the starting cyanuric chloride. Azido-acetylene monomers
1 and
2 were colorless crystalline substances with T
m = 41 − 42
oC and T
m = 57 − 58
oC, respectively, relatively stable at room temperature. The IR,
1H NMR and
13C NMR spectra of the obtained monomers coincided with the spectra of the corresponding compounds obtained previously [
14,
15].
As a result, a new general method for the synthesis of monomers 1 and 2 were developed, which makes it possible to significantly increase the yield of target products and simplify.
3.2. Preparation of HBPs
HBPs was prepared by performing a thermal azide-alkyne cycloaddition reaction (Huisgen cycloaddition) (
Scheme 3) [
13]. The resulting polymers
HBP-1 and
HBP-2 were yellow-brown glassy substances, completely soluble only in highly polar aprotic solvents, such as N,N-dimethylformamide (DMF), 1,3-dimethylamylamine (DMAA), and dimethyl sulfoxide (DMSO).
The goal of this work is the qualitative study of biological activity of polymers to assess the prospects of their use for bioapplications. Because of this, the molecular-mass and structure properties of obtaining HBPs were not considered.
3.3. Preparation Compounds for the Biological Tests
In the first step, the solubility in nutrient media of test compounds was determined. Monomers and HBPs were hydrophobic, therefore, in biological tests we used concentrated solutions of these compounds in the experimental mixture (99.9 vol.% nutrient medium/0.1 vol.% DMSO): 1 ~ 4 wt.%, HBP-1 ~ 0.75 wt.%, 2 ~ 4 wt.%, HBP-2 ~ 0.75 wt.%, 3 ~ 4 wt.%. Due to the low solubility of the test compounds, along with experiments with these solutions, experiments were carried out with solutions of nutrient media containing 1 vol.% DMSO.
Antibacterial Activity
The antibacterial activity of the compounds was observed in bacteria of the species
E. coli using the disk diffusion method (DDM). As a comparative comparison, common broad-spectrum penicillin antibiotic, ampicillin ((2S,5R,6R)-6-[(R)-2-amino-2-phenylacetamido]-3,3-dimethyl-7-oxo-4 -thia-1-azabicyclo-[3,2,0]-heptane-2-carboxylic acid) was chosen. Based on the results of the study (
Table 1), trispropargyloxy-substituted 1,3,5-triazine
3 and monoazide monomer
1 were didn’t have antibacterial activity against
E. coli. Dyazide monomer
2 in the concentration range from 0.2 to 2.5 mg/filter inhibited growth of bacteria (
E. coli growth inhibition zone width was 10 − 12 mm). Comparing the diameters of the zones of inhibition of E. coli growth for ampicillin and monomer
2, we can conclude that diazide monomer 2 is characterized by weak antibacterial activity.
Qualitatively test on volumetric samples of
HBP-1 and
HBP-2 showed that polymers have weak antibacterial activity: they reduce the density of the bacterial lawn, but do not cause the appearance of a bacteria-free zone (
Figure 1).
Series of disks impregnated with solutions of monomers in acetone were prepared for quantitative assessment of the antibacterial activity of HBPs (
Table 2). Disks were dried from the solvent and reaction of polycycloaddition was carried out at 80 °C for 24 hours. Disks with polymers were evenly laid out on the surface of the seeded agar at a distance of 2 cm from the edge of the dish. The cups were kept in a thermostat at 37 °C for 24 hours.
Analysis of the antibacterial activity of polymer films by the DDM method showed that the polymers do not exhibit activity against E. coli (the diameter of the growth inhibition zone is less than 10 mm). But initial experiments on volumetric samples showed that there is still some activity. Based on this, we can conclude that initial polymer samples have a very low concentration of active low-molecular compounds capable of diffusing into the aquatic environment in polymer samples.
As the result, it can be concluded that the presence of an azide group in the compound affects the antibacterial activity, as well as the possibility of diffusion of the low molecular weight fraction of the substance in the aqueous environment.
3.4. Cytotoxisitic Effect of Compounds
The cytotoxicity of the test compounds was studied in relation to M-HeLa, FetMSC and Vero cell lines. A qualitative analysis of the cytotoxicity of HBP showed that HeLa cells actively grew on the films of HBP-1, while on the films of HBP-2 were practically no living cells. This fact may be evidence of poor cell adhesion to the polymer surface and the toxicity of HBP-2. Quantitative analysis of polymers could not be carried out due to poor adhesion of the polymer film to the bottom of the Petri dish.
In this regard, further research was continued with solutions of the test substances. Experiments to determine the cytotoxicity of solutions were carried out using the MTT test. Based on the results of the study, dose-effect curves were constructed (
Figure 2) and the concentrations of half-maximal inhibition IC
50 of all studied samples were calculated (
Table 3).
Trispropargyloxy-substituted 1,3,5-triazine 3 showed no cytotoxic effect on M-HeLa, Vero and FetMSC cells. Diazide compound 2 had the greatest toxic effect on M-HeLa, Vero and FetMSC cells. Monazide compound 1 showed cytotoxicity to M-HeLa cells compared to Vero and FetMSC cells. HBPs had a lesser cytotoxic effect on M-HeLa cells, which can be explained by the spatial hindrances resulting from polycycloaddition for the interaction of functional groups located inside the macromolecule with the cell (its enzymes or receptors). Besides, HBP didn’t have a cytotoxic effect on normal cell lines (FetMSC and Vero). This fact indicated the safety of using HBPs for bioapplications.